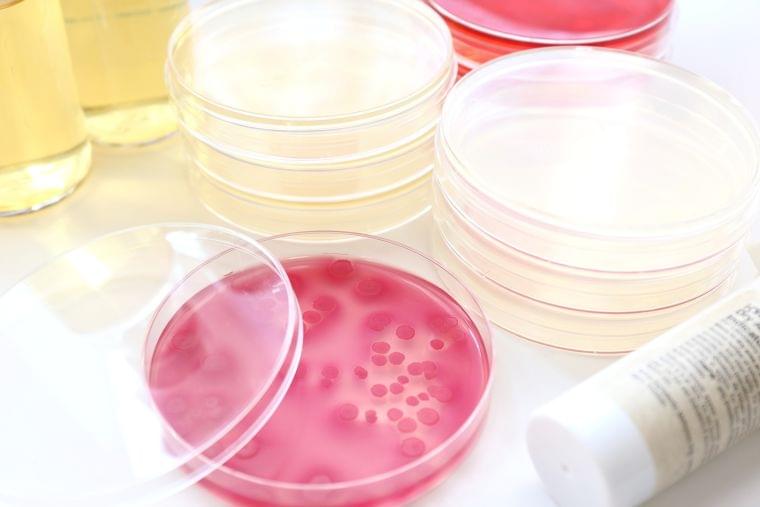
食の安全と微生物②

送信完了しました!
あなたが投稿した記事を削除しました。
あなたが投稿した相談を削除しました。
回答を締め切りました。
あなたが投稿した意見(コメント)を削除しました。
あなたの予定1件を削除しました。
クリップボードにコピーしました。
計算結果をブログや他サイトで紹介するには
コピーボタンを押して右のタグをブログや他サイトにHTMLタグとして貼付けてご利用ください。 大きさを変更したい場合は、タグ内の「max-width:400px;」の数字を変更することで、 お好みの大きさに変更できます。例)max-width:510px;
マイ食品1件を削除しました。
マイ食品1件を削除しました。
公式食品1件の終売状態を変更しました。
公式食品1件の終売状態を変更しました。
不正解をリセット
不正解の問題だけリセットしますか?
回答を全部リセット
全ての回答をリセットしますか?

連載最終回は、テレワーク中でも行える体作りについて中本絵里さんに解説していただきます。
1846日前